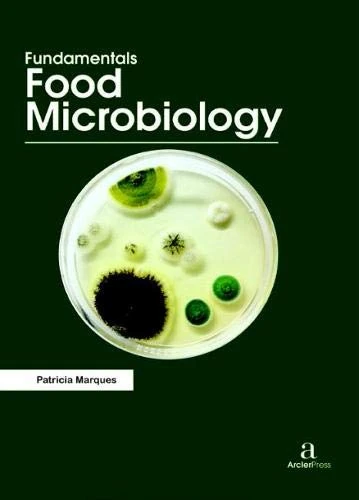
Fundamentals Food Microbiology

We can't find the internet
Attempting to reconnect
Something went wrong!
Hang in there while we get back on track

£71.56
Fundamentals of Biotechnology
Price data last checked 103 day(s) ago - refreshing...
We'll watch every seller, every day. One email when your price arrives.
This is the usual price. Wait for it to drop, or tell us your number.
£72 today · usual range £0–£0 · best ever £67
NEW HERE?
Amazon shows you one price. We show you all of them.
Tosheroon watches Amazon prices so you don't have to. Every product on Amazon has a price history — we make it visible. Set the price you'd actually pay, and we'll email you the second it gets there. No app, no account, one email.
WHAT'S ON THIS PAGE
when this has been cheap or pricey
where the price is heading next
all-time high & low, recent range
name your number, we'll email you
Price History & Forecast
Grey patches = out of stock. Cheaper = lower on the chart. Hover for exact prices.
Last 628 days • 628 data points (No recent data available)
Price Distribution
Price distribution over 628 days • 7 price levels
Price Analysis
Most common price: £73 (254 days, 40.4%)
Price range: £67 - £79
Price levels: 7 different prices over 628 days
Product Specifications
- Format
- Hardcover
- ASIN
- 1680945238
- Domain
- Amazon UK
- Release Date
- 30 November 2016
- Listed Since
- 03 November 2017
Barcode
No barcode data available
Similar Products You Might Like

Fundamentals of Molecular Biology

Fundamentals of Power Electronics

Fundamentals of Agronomy

Fundamentals of Environmentalism and Sustainability

Fundamental of Statistics

Synthetic Biology and Chemistry

Fundamentals of Web Technology

The Fundamentals of Algorithmic Processes

Fundamentals of Environmental Monitoring

Essentials of Botany
Fundamentals Food Microbiology

Introductory Biology

Computational Biology

Biorobotics in Medicine

Biochemistry - Arcler Press Science and Chemistry Book

Fundamentals of Algebra

Fundamentals of Hydraulics

Fundamentals of Plant Pathology

Library and Information Science Fundamentals

Stem Cell Biology: Fundamentals

Pharmaceutical Biotechnology

Environmental Biochemistry

Engineering Materials
